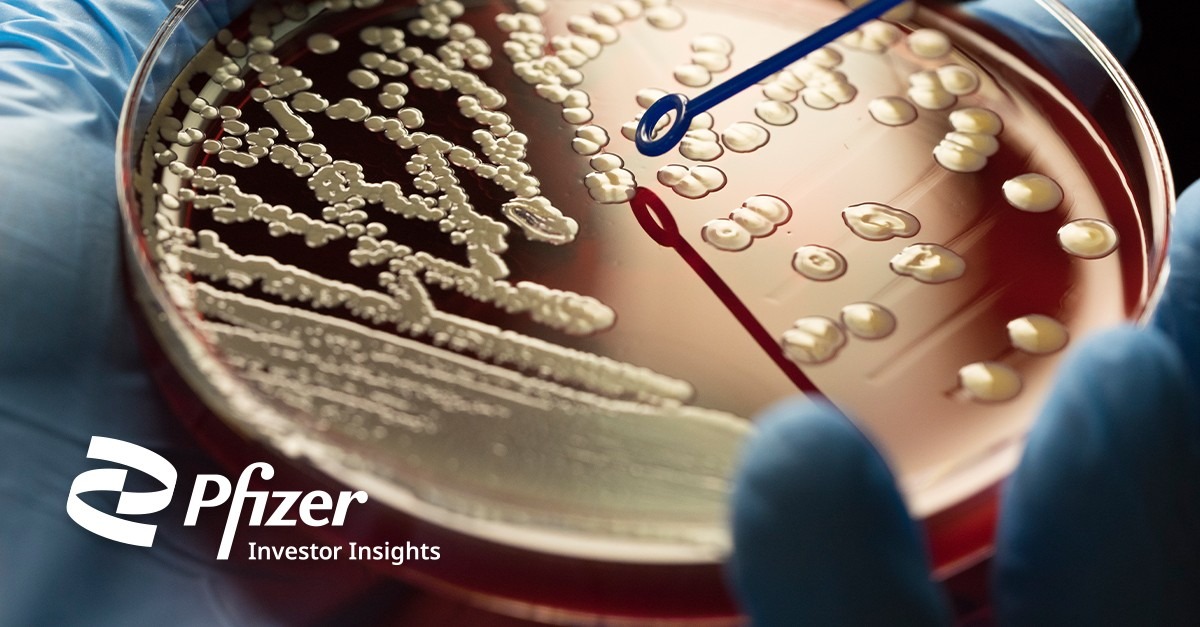
Dubai's Triple Crown: Real Estate Boom, Hedge Fund Internships, and Pfizer's Antibiotic Breakthrough

Loading market data...
Latest Top News

Dubai's Triple Crown: Real Estate Boom, Hedge Fund Internships, and Pfizer's Antibiotic Breakthrough
Dubai property market is on the rise with transactions worth AED40.98 billion recorded in February 2025 due to pro-investment policies and increasing population. Leading developers such as Emaar Properties and Ellington Properties are spearheading the movement with cutting-edge developments. On a...
Stay Ahead – Explore Now! 'Made in India: A Titan Story' Captures the Power of Resilience
















